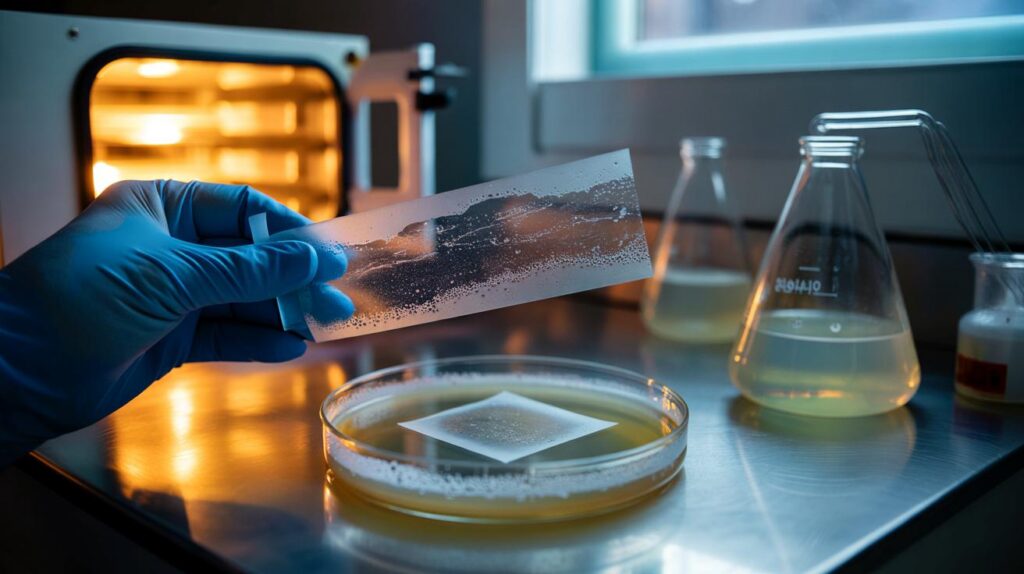
Swedish researchers find a bacterium that breaks down PET plastic in record time

Swedish researchers find a bacterium that breaks down PET plastic in record time
A rush of hope in a lab that smells faintly of ethanol and warm plastic: Swedish researchers say they’ve found a bacterium that tears through PET — the stuff of bottles and polyester — in record time. Not in years. […]